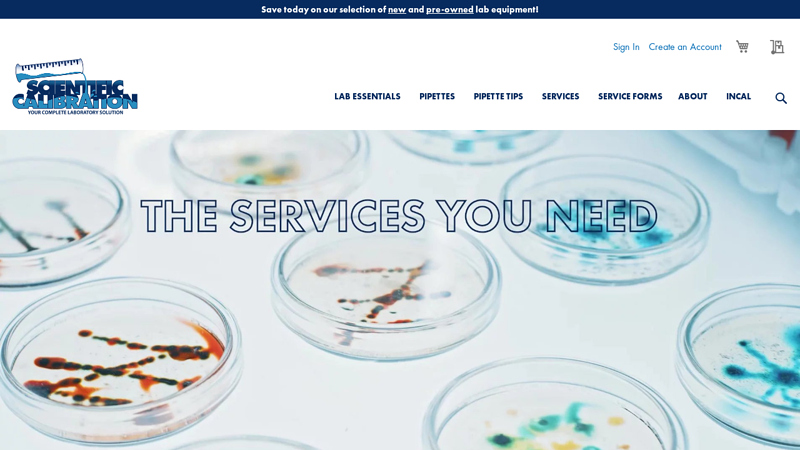
Scientific Calibration Homepage

The global precision calibration equipment market is experiencing robust growth, driven by increasing demand for accuracy and compliance across industries such as aerospace, pharmaceuticals, automotive, and manufacturing. According to Grand View Research, the market was valued at USD 1.72 billion in 2022 and is projected to expand at a compound annual growth rate (CAGR) of 5.8% from 2023 to 2030. This growth is fueled by stringent regulatory standards, rising automation, and the need for traceable measurements in quality assurance processes. As industries prioritize precision and repeatability, the role of reliable calibration equipment manufacturers has become more critical than ever. In this landscape, a select group of companies stands out for their technological innovation, global reach, and comprehensive service offerings. Based on market presence, product portfolio breadth, and industry reputation, the following eight manufacturers are leading the charge in shaping the future of precision calibration.
Top 8 Precision Calibration Manufacturers 2026
(Ranked by Factory Capability & Trust Score)
#1 Micro Precision Calibration
Domain Est. 1996
Website: microprecision.com
Key Highlights: Micro Precision is a one-stop shop for equipment service solutions. We offer calibration, repair, global services, and test equipment solutions to customers….
#2 Mitutoyo America Corporation
Domain Est. 1996
Website: mitutoyo.com
Key Highlights: High Precision Calibration Lab. Our ISO/IEC 17025 accredited laboratory delivers the precision calibration services you can trust to maintain accuracy on all ……
#3 Scientific Calibration Homepage
Domain Est. 1997
Website: scical.com
Key Highlights: Scientific Calibration provides comprehensive in-house and on-site calibration services for a wide range of laboratory equipment….
#4 Precision Calibration & Repair
Domain Est. 2004
Website: precal.net
Key Highlights: Houston’s leading ISO-certified experts in calibration and repair for inspection, measuring, and testing equipment. Precision and accuracy guaranteed….
#5 Trescal
Domain Est. 2004
Website: trescal.com
Key Highlights: Trescal is the global leader in calibration services. A single-source provider for measurement, repair and asset management across the globe….
#6 Precision Calibration Experts in Connecticut
Domain Est. 2009
Website: garbermetrology.com
Key Highlights: Our Precision Calibration Solutions. The technicians at Garber Metrology can provide various calibration services to support accuracy in your processes….
#7 Precision Calibration Systems
Domain Est. 2010
Website: pcsllctn.com
Key Highlights: We are a full-service ISO 17025 accredited calibration laboratory with the goal of providing reliable and accurate instrument calibration services….
#8 API Metrology: Metrology Products and Services
Domain Est. 2018
Website: apimetrology.com
Key Highlights: “API also provides ISO 17025 accredited portable metrology inspection and calibration services”…
Expert Sourcing Insights for Precision Calibration

H2: 2026 Market Trends for Precision Calibration
The precision calibration market in 2026 is poised for significant transformation, driven by technological convergence, evolving regulations, and increasing demands for quality and traceability across critical industries. Here are the key trends shaping the landscape:
1. Accelerated Adoption of Automation and AI-Driven Calibration:
* Robotic Integration: Expect wider deployment of robotic arms and automated test stands in calibration labs, particularly for high-volume, repetitive tasks (e.g., pressure gauges, multimeters). This boosts throughput, reduces human error, and improves repeatability.
* AI & Machine Learning (ML): AI will move beyond basic data analysis. Predictive algorithms will forecast instrument drift and optimize calibration intervals, shifting from time-based to condition-based calibration. ML will enhance uncertainty analysis, identify subtle measurement anomalies, and automate report generation.
* Smart Calibration Systems: Integrated platforms will combine hardware, software, and AI to manage the entire calibration lifecycle (scheduling, execution, data analysis, reporting, traceability) with minimal manual intervention.
2. Cloud-Based Calibration Management & Digital Twins:
* Dominance of Cloud Platforms: SaaS (Software-as-a-Service) calibration management software (LIMS/MES) will become the standard. This enables real-time access to calibration data, remote monitoring, centralized control across global facilities, seamless updates, and improved collaboration.
* Digital Twin Integration: Calibration data will feed into digital twins of physical assets and processes. This allows for real-time validation of sensor accuracy within the digital model, improving process simulation accuracy and predictive maintenance efficacy in industries like aerospace and advanced manufacturing.
3. Heightened Focus on Traceability, Data Integrity, and Cybersecurity:
* Blockchain for Immutability: While still emerging, blockchain technology will see pilot projects and initial adoption to create tamper-proof, transparent, and auditable calibration records, crucial for heavily regulated industries (pharma, aerospace, defense).
* Enhanced Data Security: As calibration data moves to the cloud and integrates with broader IT/OT systems, robust cybersecurity measures (encryption, access controls, zero-trust architectures) will be non-negotiable to protect sensitive measurement data and prevent tampering.
* Regulatory Scrutiny: Standards bodies (ISO, ILAC, NIST) and regulators will place greater emphasis on data integrity (ALCOA+ principles), driving demand for systems with robust audit trails and electronic signatures.
4. Industry-Specific Drivers and Demands:
* Semiconductors & Advanced Electronics: The relentless push for smaller nodes and complex packaging demands extreme precision (nanometers, picoseconds). Calibration will focus on ultra-low uncertainty for critical metrology tools (CD-SEMs, overlay tools, probe stations) and ESD-sensitive environments.
* Pharmaceuticals & Biotech: Stringent FDA/EMA requirements and the rise of personalized medicine (e.g., cell & gene therapy) necessitate highly reliable calibration of environmental monitoring systems (temperature, humidity, pressure), bioreactors, and analytical instruments (HPLC, mass specs) with full data integrity.
* Electric Vehicles (EVs) & Battery Tech: The EV boom drives demand for precise calibration of battery testers, motor analyzers, power electronics test equipment, and charging infrastructure, focusing on high-voltage, high-current, and dynamic performance measurements.
* Aerospace & Defense: Safety-critical applications demand the highest levels of traceability and reliability. Calibration of avionics, navigation systems, structural test equipment, and additive manufacturing (3D printing) systems will require advanced techniques and rigorous documentation.
5. Growth in In-Process and On-Site Calibration:
* Minimizing Downtime: The cost of taking equipment offline for calibration is driving demand for faster, more efficient on-site services and portable calibration standards.
* In-Situ Calibration: Techniques allowing calibration verification or adjustment while equipment remains installed and operational (e.g., in refineries, power plants) will gain traction, supported by wireless sensors and remote monitoring.
6. Sustainability and Green Calibration:
* Energy Efficiency: Calibration labs and equipment manufacturers will focus on reducing the energy footprint of calibration processes and standards.
* Sustainable Practices: Emphasis on reducing waste (chemicals, packaging), optimizing logistics for on-site services, and extending the lifespan of calibrated assets through predictive maintenance.
Conclusion for H2 2026:
The precision calibration market in 2026 will be characterized by intelligent, connected, and automated systems. Success will depend on embracing digitalization (cloud, AI, digital twins), ensuring ironclad data integrity and security, meeting the hyper-specific demands of advanced industries, and offering flexible service models (on-site, predictive). Vendors who integrate seamlessly into clients’ digital ecosystems and provide actionable insights from calibration data, rather than just a certificate, will lead the market. The focus will shift from compliance to value creation through optimized performance, reduced risk, and enhanced innovation capabilities.

Common Pitfalls Sourcing Precision Calibration Services (Quality and IP Risks)
Sourcing precision calibration services is critical for maintaining measurement accuracy and ensuring product quality, regulatory compliance, and operational integrity. However, organizations often encounter significant pitfalls—particularly in the areas of quality assurance and intellectual property (IP) protection—that can compromise results and expose the business to risk.
Inadequate Quality Assurance and Traceability
One of the most frequent issues is selecting a provider without robust, verifiable quality systems. Calibration results are only as reliable as the standards and processes used. Organizations often fail to verify that the service provider maintains:
- Accreditation to recognized standards (e.g., ISO/IEC 17025)
- Proper measurement traceability to national or international standards (e.g., NIST, PTB)
- Regular equipment recalibration and documented uncertainty budgets
Using a non-accredited or poorly audited lab can lead to inaccurate calibrations, resulting in faulty product measurements, failed audits, or regulatory non-compliance.
Poor Documentation and Reporting
Insufficient or inconsistent calibration reports are a major quality red flag. Many providers deliver minimal documentation lacking:
- Measurement uncertainties
- As-found/as-left data
- Environmental conditions during calibration
- Detailed equipment identifiers and serial numbers
Without comprehensive reports, organizations cannot fully assess equipment performance history or demonstrate compliance during audits, undermining the value of the calibration process.
Lack of Industry-Specific Expertise
Precision calibration requirements vary significantly across industries (e.g., aerospace, medical devices, semiconductor manufacturing). A common mistake is choosing a generalist provider without domain-specific knowledge. This can lead to:
- Misapplication of calibration procedures
- Inappropriate tolerance levels
- Non-compliance with industry-specific standards (e.g., FDA 21 CFR Part 11, AS9100)
Without specialized expertise, even technically accurate calibrations may not meet operational or regulatory needs.
Intellectual Property Exposure
Calibration often involves sharing sensitive equipment, proprietary designs, or unique measurement processes. A key IP risk arises when providers:
- Lack robust confidentiality agreements (NDAs) or data protection policies
- Fail to secure physical and digital access to calibrated devices
- Retain or reuse calibration data without permission
Equipment sent for calibration may contain trade secrets or patented technology, making it vulnerable if the provider operates in a less secure environment or shares facilities with competitors.
Inconsistent Service Delivery and Turnaround Times
Unreliable scheduling and extended turnaround times can disrupt operations, particularly in high-uptime environments. Some providers lack capacity planning or fail to communicate delays, leading to unplanned downtime. This inconsistency reflects poor quality management and impacts production timelines.
Overlooking Cybersecurity in Digital Calibration Data
With the increasing use of digital calibration systems and cloud-based data management, providers may expose clients to cybersecurity risks. If a provider stores calibration records in inadequately secured systems, there is potential for:
- Unauthorized access to sensitive technical data
- Data breaches involving proprietary performance metrics
- Loss or corruption of calibration history
Ensuring the provider follows cybersecurity best practices (e.g., encryption, access controls, regular audits) is essential to protect digital IP.
Failure to Audit or Vet Third-Party Subcontractors
Some calibration providers outsource work to subcontractors without client knowledge. This introduces uncontrolled variables in quality and IP protection. Without visibility into the full calibration chain, organizations cannot ensure consistent standards or protect sensitive information across all touchpoints.
Conclusion
To avoid these pitfalls, organizations must rigorously evaluate calibration providers not only on price and convenience but also on quality systems, industry expertise, data security, and IP safeguards. Conducting on-site audits, reviewing certifications, and establishing clear contractual terms around confidentiality and data ownership are essential steps in mitigating risk and ensuring reliable, secure calibration services.

Logistics & Compliance Guide for Precision Calibration
This guide outlines the essential logistics and compliance procedures for conducting precision calibration services, ensuring accuracy, traceability, and adherence to industry standards.
Scope and Applicability
This guide applies to all personnel involved in the logistics, handling, calibration, and documentation of precision instruments at Precision Calibration. It covers in-house, on-site, and third-party calibration operations.
Regulatory and Standards Compliance
Precision Calibration complies with the following key regulations and standards:
– ISO/IEC 17025:2017 – General requirements for the competence of testing and calibration laboratories
– ANSI/NCSL Z540.3 – Requirements for calibration laboratories
– ISO 9001:2015 – Quality management systems
– NIST traceability requirements for measurement standards
– Applicable local, state, and federal regulations (e.g., OSHA, EPA for hazardous materials, if applicable)
All calibration processes must maintain documented traceability to national or international standards.
Equipment Handling and Transportation
- Packaging: Instruments must be packed using anti-static, shock-absorbent materials in sealed, labeled containers. Include desiccants if sensitive to moisture.
- Labeling: Each package must display:
- Unique tracking number
- Instrument ID
- “Fragile – Precision Instrument”
- Handling instructions (e.g., “This Side Up”)
- Transportation: Use only certified carriers with experience in handling sensitive equipment. Maintain temperature and humidity within instrument specifications during transit.
- Chain of Custody: Document all transfers of custody with timestamps, signatures, and condition reports.
Calibration Environment Requirements
- Laboratory Conditions:
- Temperature: 20°C ±1°C (68°F ±2°F), monitored continuously
- Humidity: 45–55% RH, logged hourly
- Vibration: Isolated workbenches with vibration-damping mounts
- ESD Protection: Grounded workstations and personnel
- Environmental data must be recorded and retained with each calibration report.
Calibration Process Controls
- Only authorized, trained technicians may perform calibrations.
- All reference standards must be:
- Certified and within their calibration validity period
- Traceable to NIST or equivalent national metrology institute
- Stored and used under specified environmental conditions
- Calibration procedures must follow documented, approved methods (SOPs).
- Deviations from procedures require formal approval and documentation.
Documentation and Recordkeeping
- Calibration Certificate must include:
- Unique certificate number
- Customer and instrument details
- Date of calibration and next due date
- Environmental conditions
- As-found and as-left data
- Measurement uncertainties
- Statement of traceability
- Technician and reviewer signatures
- All records must be retained for a minimum of seven (7) years in secure digital and backup formats.
Non-Conformance and Corrective Actions
- Any out-of-tolerance conditions or procedural deviations must be reported immediately.
- Initiate a Non-Conformance Report (NCR) and conduct root cause analysis.
- Implement corrective and preventive actions (CAPA) using approved forms.
- Notify customer promptly if instrument performance is affected.
On-Site Calibration Logistics
- Coordinate access, power, and environmental conditions with the client in advance.
- Transport mobile calibration kits in climate-controlled vehicles.
- Perform on-site environmental monitoring and document conditions.
- Ensure client personnel are briefed on safety and equipment handling.
Training and Competency
- All personnel must complete initial and annual refresher training in:
- Calibration procedures
- Safety protocols
- Data integrity and compliance
- Equipment handling
- Maintain training records and competency assessments.
Audit and Continuous Improvement
- Internal audits conducted quarterly to assess compliance.
- Management reviews held biannually to evaluate performance and drive improvement.
- Client feedback integrated into service enhancements.
Revision History
| Version | Date | Changes Made | Approved By |
|———|————|—————————-|——————-|
| 1.0 | 2023-10-01 | Initial Release | Quality Manager |
| 1.1 | 2024-03-15 | Updated transport standards | Compliance Officer|
Conclusion for Sourcing Precision Calibration Services
In conclusion, sourcing precision calibration services is a critical component in maintaining the accuracy, reliability, and compliance of measurement instruments across industries such as manufacturing, aerospace, pharmaceuticals, and metrology. Selecting the right calibration provider requires careful evaluation of technical expertise, accreditation (such as ISO/IEC 17025), traceability to national or international standards, turnaround time, and cost-effectiveness.
A strategic sourcing approach ensures not only compliance with regulatory requirements but also enhances product quality, reduces operational risks, and supports long-term efficiency. By partnering with qualified and reputable calibration providers, organizations can achieve consistent measurement integrity, minimize downtime, and maintain competitive advantage in quality-driven markets. Ultimately, investing in precision calibration is an investment in accuracy, trust, and operational excellence.